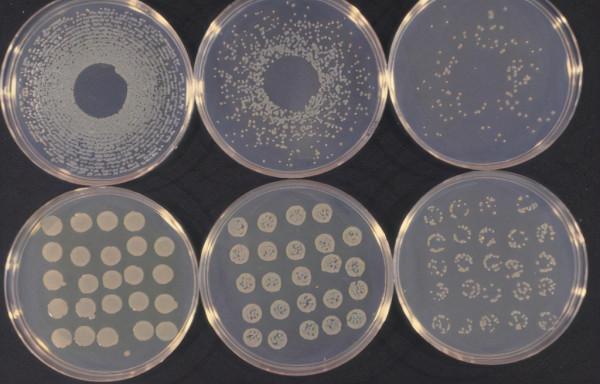
什麼是奈米發電機？奈米科技其它領域的應用有哪些？

奈米發電機和來自小規模物理機械能和熱能透過將電動是用於轉換的技術。奈米發電機有三種典型型別:壓電,摩擦電和熱電。前兩者使用機械能,而後者則根據暫時的溫度波動進行熱能收集。
壓電奈米發電機
壓電奈米發生器和壓電奈米結構透過利用成電能在環境轉換動能本能量收集是一個裝置。這是2006年宣佈的xxx臺奈米發電機。術語“奈米發電機”不限制其使用的能源型別(包括太陽能和熱能),但最通常指的是這種方法。
儘管它仍處於開發的早期階段,但是預計它將在將來為能量收集器的小型化帶來突破,並將補充其他型別的收集器為行動式電子裝置開發獨立的電源。
應用
壓電奈米發電機有望應用於由週期性運動產生能量的廣泛環境中。例如,大的來自風和海浪,小的來自心跳和呼吸中的肌肉運動。預期將實現的其他應用包括以下內容。
自供電的奈米/微型裝置
在動能豐富的環境中操作能耗相對較低的奈米/微型裝置時,使用奈米發電機作為自供電或輔助能源被認為是有希望的。2010年,Wan等人將輸出電壓為20-40 mV的VING整合到pH感測器或UV感測器中,以實現自供電。
但是,與奈米和微型裝置的功耗相比,奈米發電機產生的電能很小,其應用範圍目前僅限於電池輔助能源。求突破,奈米發電機太陽能電池研究與另一種型別的收集裝置,組合如生化能量採集正在進行。預計這種方法將導致能源的發展,例如自供電必不可少的智慧粉塵。
智慧可穿戴系統
在由結合有壓電纖維的織物製成的衣服中的應用也是有希望的。從體育鍛煉中獲得的動能透過壓電纖維轉換為電能,該壓電纖維被用作具有內建裝置(例如健康監測系統)的智慧可穿戴系統(英文版)的能源。還可以想象的是,諸如VING之類的奈米發電機內建在鞋子中,可以輕鬆地從行走中產生動力。
類似的應用領域是具有發電功能的人造面板。Wang等人表明,交流電壓高達100毫伏可以透過執行貼上SWG柔性倉鼠來生成。
透明的柔性裝置
一些壓電奈米結構可以被製造在柔性和透明的有機基板上。SKKU的Kim和SAIT的Cho以及其他人開發了一種透明而靈活的奈米發電機。將來,期望透過將其結合到自供電的觸覺感測器中來實現節能觸控式螢幕裝置。木村進一步發展的裝置中,氧化銦錫(ITO)是電極的石墨烯具有改進的清晰度和成本效益,而代以層 。
植入式遙測能量接收器
基於ZnO奈米線的奈米發電機也可以用作可植入裝置。由於ZnO本身具有生物相容性,並且可以在有機基板上製造,因此整個裝置具有生物相容性。配備有奈米發電機的人類可植入裝置可以透過利用壓電奈米結構將來自外部的超聲振動轉換為電能來進行操作。
奈米流體
奈米流體是流體含有奈米尺度的顆粒,稱為奈米顆粒。這些流體是奈米粒子在基礎流體中的工程膠體懸浮液。用於奈米流體的奈米顆粒通常由金屬、氧化物、碳化物或碳奈米管制成。常見的基礎油包括水、乙二醇和油。
奈米流體具有新的特性,使它們在傳熱方面的許多應用中具有潛在的用途,包括微電子、燃料電池、製藥過程和混合動力發動機,發動機冷卻/車輛熱管理、家用冰箱、冷卻器、熱換熱器、研磨、機加工和鍋爐煙氣降溫。與基液相比,它們表現出增強的熱導率和對流傳熱係數。流變學知識發現奈米流體的行為對於決定它們是否適用於對流傳熱應用至關重要。奈米流體還具有特殊的聲學特性,並且在超聲場中顯示出入射壓縮波的額外剪下波再轉換;隨著濃度的增加,效果會更加明顯。
在計算流體動力學(CFD)等分析中,可以假設奈米流體是單相流體;然而,幾乎所有新的學術論文都使用兩階段假設。可以應用單相流體的經典理論,其中奈米流體的物理特性被視為成分及其濃度的特性的函式。另一種方法使用雙組分模型模擬奈米流體。
透過擴散在接觸線附近組裝的奈米顆粒的固體狀有序結構增強了奈米流體液滴的擴散,這在接觸線附近產生了結構分離壓力。然而,對於奈米級直徑的小液滴,沒有觀察到這種增強,因為潤溼時間尺度遠小於擴散時間尺度。
銀奈米
銀奈米 銀奈米 Silver Nano(銀奈米健康系統)是三星於2003年4月推出的一種抗菌技術的商標名稱,該技術在洗衣機、冰箱、空調、空氣清淨機和真空吸塵器中使用銀奈米粒子。
奈米孔
奈米孔 奈米孔是奈米大小的孔。例如,它可能由孔隙形成蛋白或矽或石墨烯等合成材料上的空穴產生。 當奈米孔存在於電絕緣膜中時,它可以用作單分子探測器。它可以是高電阻脂質雙層中的生物蛋白質通道,固態膜中的孔隙或這些孔隙——在合成膜中設定的蛋白質通道。檢測原理基於監測電壓透過奈米孔的離子電流,因為電壓透過薄膜。當奈米孔具有分子尺寸時,分子(例如DNA)的透過會導致“開放”電流水平的中斷,導致“易位事件”訊號。例如,RNA或單鏈DNA分子透過膜嵌入的α溶血素通道(直徑1.5奈米)會導致電流阻塞約90%(以1 M KCl溶液測量)。
奈米孔測序
奈米孔測序 奈米孔測序是第三代方法,用於生物聚合物的測序,特別是DNA或RNA形式的多核苷酸。 使用奈米孔測序,可以對單個DNA或RNA分子進行測序,而無需對樣品進行PCR放大或化學標記。在以前開發的任何測序方法中,上述步驟中至少有一個是必要的。奈米孔測序具有提供相對低成本的基因分型、高測試遷移率和...
奈米線電池
奈米線電池 使用的奈米線,以增加其一個或兩個的表面面積的電極。鋰離子電池的某些設計(矽、鍺和過渡金屬氧化物)已經發布,但都沒有市售。所有這些概念都取代了傳統的石墨陽極,可以改善電池效能。
矽奈米線
矽奈米線 矽奈米線,也稱為SiNW,是最常由矽前體透過蝕刻固體或透過從氣相或液相催化生長而形成的半導體奈米線。這樣的奈米線在鋰離子電池、熱電和感測器中具有有希望的應用。矽奈米線的初始合成通常伴隨著熱氧化步驟,以產生具有精確定製的尺寸和形態的結構。 矽奈米線具有獨特的特性,這在塊狀(三維)矽材料中是看不到的。這些特性來自不尋常的準一維電子結構,是眾多學科和應用研究的主題。矽奈米線被認為是最重要的一維材料之一,是因為它們可以充當組裝奈米級電子產品的基礎,而無需複雜而昂貴的製造設施。矽奈米線被廣泛研究用於光伏、奈米線電池、熱電和非易失性儲存器等應用。
奈米球電池
奈米球電池 奈米球電池是一種實驗型別的電池,其陰極或陽極由奈米球製成,奈米球可以由各種材料(例如碳和磷酸鐵鋰)組成。使用奈米技術的電池比常規電池具有更大的功能,這是因為表面積得到了極大的改善,從而可以實現更好的電氣效能,例如快速充電和放電。 2009年,麻省理工學院的研究人員能夠使用此技術在10秒內為一個簡單的磷酸鐵鋰奈米球電池充電。從理論上講,這將允許小型電子裝置快速充電,而大型電池仍將受到市電的限制。
奈米孔電池
奈米孔電池 奈米孔電池是可再充電電池是數十億的基板的孔隙內形成的奈米級的電池的複合物。 奈米孔電池孔內的空間是如此之小,以至於數十億個孔的總和等於一粒沙的體積。每個孔的直徑約為人發寬度的八十分之一。 奈米孔電池的製作 2014年,演示裝置由陽極鋁製成的陶瓷片製成。它擁有兩個被電解質隔開的五氧化二釩奈米管電極,該電解質在兩者之間攜帶電荷。集電器由釕製成。各個電池並聯連線。
奈米啞鈴
什麼是奈米啞鈴 奈米啞鈴,是一對連線在一起的球體,可以是二氧化矽或氧化鋅的。 它們已在普渡大學的實驗中使用,使它們在真空中以每分鐘600億轉的速度旋轉。 奈米啞鈴首先在實驗室中使用水熱過程建立。最終的啞鈴由兩個連線的二氧化矽球組成,使其長320奈米,寬約170奈米。奈米啞鈴也正在研究中,可能用於光動力療法(一種治療癌症的方法)中。
奈米細菌
奈米細菌,是先前提議的一類活生物體(特別是細胞壁微生物)的單位或成員名稱,現在已經不合格了,其尺寸遠小於普遍接受的壽命下限(對於細菌,如支原體,約為200 nm)。最初根據在地質構造中(觀察到的奈米級結構,包括一個隕石),奈米細菌的狀態是有爭議的,一些研究人員表明它們是一類新生物體的能夠合併放射性標記的尿苷,其他歸因於它們的簡單,非生物性質。
奈米粒子
通常被定義為的顆粒物質是1個100之間的奈米在(nm)的直徑。該術語有時用於較大的顆粒,xxx500 nm,或僅在兩個方向上小於100 nm的纖維和管子。在最低範圍,通常將小於1 nm的金屬粒子稱為原子簇。
奈米顆粒通常與微粒(1-1000 µm),“細顆粒”(尺寸在100至2500 nm之間)和“粗顆粒”(範圍從2500至10,000 nm)區分開,因為它們的較小尺寸會驅動非常不同的物理或化學作用特性,例如膠體特性和光學或電特性。
它們更容易受到布朗運動的影響,通常不會沉澱,就像通常被理解為1到1000 nm的膠體顆粒一樣。
由於奈米粒子比可見光的波長(400-700 nm)小得多,因此無法用普通的光學顯微鏡看到,需要使用電子顯微鏡。出於同樣的原因,奈米粒子在透明介質中的分散可以是透明的,而較大粒子的懸浮液通常會散射入射到其上的部分或全部可見光。奈米顆粒還容易地透過普通的過濾器,如普通陶瓷蠟燭,以便從液體中的分離需要特殊的納濾技術。
奈米粒子的性質通常與相同物質的較大粒子的性質明顯不同。由於原子的典型直徑在0.15到0.6 nm之間,因此奈米顆粒材料的很大一部分位於距其表面幾個原子直徑之內。因此,該表面層的效能可能優於塊狀材料的效能。對於分散在不同組成的介質中的奈米粒子而言,此效果特別強,因為兩種材料在其介面處的相互作用也變得顯著。
奈米粒子在自然界廣泛存在,是許多科學領域的研究物件,例如化學、物理學、地質學和生物學。處於散裝材料與原子或分子結構之間的過渡時,它們經常表現出在任何規模上都未觀察到的現象。它們是大氣汙染的重要組成部分,並且是許多工業產品(如油漆、塑膠、金屬、陶瓷和磁性產品)中的關鍵成分文章。具有特定效能的奈米顆粒的生產是奈米技術的重要分支。
通常,與大體積奈米粒子相比,奈米粒子的小尺寸導致點缺陷的濃度較低[7],但它們確實支援各種位錯,這些位錯可以使用高解析度電子顯微鏡觀察。然而,奈米粒子表現出不同的位錯力學,連同其獨特的表面結構,導致其機械效能不同於散裝材料。
奈米粒子的各向異性導致奈米粒子的性質發生許多變化。金、銀和鉑的非球形奈米粒子由於其令人著迷的光學特性而被發現具有多種應用,並且在研究領域中引起了極大興趣。奈米稜鏡的非球形幾何形狀導致膠體溶液具有較高的有效橫截面和更深的顏色。透過在分子標記領域,生物分子測定,痕量金屬檢測和奈米技術應用中使用這些奈米粒子,透過調節粒子的幾何形狀來改變共振波長的可能性非常有趣。各向異性奈米粒子在非偏振光下顯示出特定的吸收行為和隨機粒子取向,從而為每個可激發軸顯示出不同的共振模式。可以基於以下事實來解釋該性質:在每天的基礎上,這些奈米顆粒的合成領域中正在取得新進展,以高產率製備它們。
奈米醫學
奈米醫學是奈米技術的醫學應用。奈米醫學的範圍從奈米材料和生物裝置的醫學應用到奈米電子生物感測器,甚至是分子奈米技術(如生物機器)的未來可能應用。對於奈米目前存在的問題涉及認識有關問題的毒性和環境影響的奈米材料(材料,其結構是奈米,一個的即十億規模計)。
透過將奈米材料與生物分子或結構連線,可以將功能新增到奈米材料中。奈米材料的大小類似於大多數生物分子和結構的大小。因此,奈米材料可用於體內和體外生物醫學研究和應用。迄今為止,奈米材料與生物學的整合已導致診斷裝置、造影劑、分析工具、物理治療應用和藥物輸送工具的發展。
奈米醫學致力於在不久的將來提供一套有價值的研究工具和臨床有用的裝置。所述的國家奈米技術計劃預計,在新的商業應用製藥工業,其可以包括先進的藥物遞送系統、新的療法和體內成像。奈米醫學的研究正在接受美國國立衛生研究院共同基金計劃的資助,該專案支援四個奈米醫學發展中心。
2015年,奈米醫學的銷售額達到160億美元,每年至少要投資38億美元用於奈米技術的研發。近年來,全球對新興奈米技術的資金每年增長45%,2013年產品銷售額超過1萬億美元。隨著奈米醫學產業的持續增長,預計它將對經濟產生重大影響
浸筆式奈米光刻
浸筆式奈米光刻(DPN)是一種掃描探針光刻技術,其中原子力顯微鏡(AFM)尖端用於使用多種墨水在一系列物質上直接建立圖案。該技術的一個常見示例是使用鏈烷硫醇鹽壓印在金表面上。該技術允許在100 奈米以下的規模上進行表面構圖 。DPN是蘸水筆(也稱為鵝毛筆)的奈米技術類似物,原子力顯微鏡的懸臂尖端位於其中用作“筆”,塗有用作“油墨”的化合物或混合物,並與基材“紙”接觸。
浸筆式奈米光刻能夠以靈活的方式將奈米級材料直接沉積到基板上。最近的進展表明,使用55,000個尖端的二維陣列進行了大規模的並行構圖。目前,該技術的應用範圍涵蓋化學、材料科學和生命科學,包括超高密度生物奈米陣列和附加光掩模修復等工作。
奈米機電系統質譜儀
什麼是奈米機電系統質譜儀 奈米機電系統質譜儀(NEMS-MS)是一種儀器透過檢測由在所述顆粒的吸附的頻移測量分析物顆粒的質量NEMS諧振器。 NEMS-MS是由加利福尼亞理工學院的Michael Roukes教授和Kamil Ekinci博士於1999年發明的。
奈米機電繼電器
奈米機電繼電器,是電致動的開關,其在內建奈米使用規模的半導體制造技術。它們被設計為替代傳統半導體邏輯或與傳統半導體邏輯結合使用。NEM繼電器的機械特性使它們的開關速度比固態繼電器慢得多,但它們具有許多有利的特性,例如零電流洩漏和低功耗,這使其有可能在下一代計算中使用。
典型的NEM繼電器需要數十伏的電勢才能“拉入”,並具有數千兆歐的接觸電阻。用鉑塗覆接觸表面可以將可實現的接觸電阻降低至3kΩ。與電晶體相比,NEM繼電器的開關速度相對較慢,約為納秒。
奈米機電系統
奈米機電系統(NEMS)是一類在奈米級集成了電氣和機械功能的裝置。奈米機電系統由所謂的微機電系統或奈米機電系統器件構成了下一步的邏輯小型化步驟。NEMS通常將類似於電晶體的奈米電子器件與機械致動器、泵或電動機整合在一起,從而可以形成物理、生物和化學感測器。該名稱源自奈米範圍內的典型器件尺寸,從而導致低質量,高機械共振頻率以及潛在的大量子力學效應(例如零點運動),以及高的表面體積比,可用於基於表面的感測機制。應用包括加速度計和感測器,以檢測空氣中的化學物質。
奈米生物技術
奈米生物技術,是指的交叉方面的奈米技術和生物。鑑於該主題是直到最近才出現的一個主題,生物奈米技術和奈米生物技術是各種相關技術的統稱。
該學科有助於表明生物學研究與奈米技術各個領域的融合。透過奈米生物學增強的概念包括:奈米裝置、奈米粒子和在奈米技術領域內發生的奈米尺度現象。這種生物學的技術方法使科學家能夠想象並建立可用於生物學研究的系統。受生物啟發的奈米技術利用生物系統作為尚未創造的技術的靈感。但是,與奈米技術和生物技術一樣,奈米生物技術確實存在許多潛在的倫理問題 與之相關。
奈米生物學中最常見的最重要目標涉及將奈米工具應用於相關的醫學/生物學問題並完善這些應用。為醫學和生物學目的開發新的工具,如類肽奈米片是奈米技術的另一個主要目標。通常,透過改進已經使用的奈米工具的應用來製造新的奈米工具。天然生物分子、生物膜和組織的成像也是奈米生物學研究人員的主要課題。與奈米生物學有關的其他主題包括懸臂陣列感測器的使用以及奈米光子學在活細胞中操縱分子過程的應用。
近來,使用微生物來合成功能性奈米粒子引起了極大的興趣。微生物可以改變金屬的氧化態。這些微生物過程開闢了新的機會,我們探索新的應用,例如,金屬奈米材料的生物合成。與化學和物理方法相比,用於合成奈米材料的微生物工藝可以在溫和且環境友好的條件下在水相中實現。這種方法已成為當前綠色生物技術在可持續發展方面的研究重點。
奈米片
什麼是奈米片 奈米片的典型示例是石墨烯,這是最薄的(0.34 nm)二維材料。該碳原子的六邊形網格是透過形成單層薄片以的形式排列而獲得的。
奈米光刻
奈米光刻是奈米技術中涉及奈米級結構工程(蝕刻、書寫、印刷)的技術領域中一個不斷髮展的領域。在希臘語中,該單詞可分為三個部分:“ nano”表示矮人,“ lith”表示石頭,“ graphy”表示書寫,或者“ tiny Writing on stone”。如今,這個詞已經演變為涵蓋10 -9至10 -6米範圍內的結構或奈米範圍內的結構的設計。本質上,場是光刻的衍生,僅涵蓋明顯較小的結構。所有奈米光刻技術都可以分為兩類:一類是蝕刻掉留下所需結構的分子的技術,另一類是將所需結構直接寫入表面的技術(類似於3D印表機建立結構的方式)。
奈米光刻領域的誕生是出於增加積體電路中電晶體數量以維持摩爾定律的需要。雖然光刻技術自18世紀末開始出現,但直到1950年代中期才將其應用於奈米級結構。隨著半導體工業的發展,對能夠生產微米級和奈米級結構的技術的需求猛增。光刻應用到這些結構首次於1958年開始奈米光刻技術的時代。從那時起,光刻已成為最成功的商業技術,能夠產生100 nm以下的圖案。與該領域相關的幾種技術,每種旨在滿足其在醫療和半導體行業中的多種用途。該領域的突破為奈米技術的發展做出了重要貢獻,並且隨著對越來越小的計算機晶片的需求的增加,今天的重要性越來越重要。進一步的研究領域涉及該領域的物理侷限性,能量收集和光子學。
奈米化學
奈米化學是化學和奈米科學的結合。奈米化學與結構單元的合成有關,後者取決於尺寸、表面、形狀和缺陷性質。奈米化學被用於化學、材料和物理、科學以及工程、生物和醫學應用。奈米化學和其他奈米科學領域具有相同的核心概念,但是這些概念的用法不同。
當科學家觀察到材料在奈米級尺寸上發生奇異變化時,將奈米字首賦予奈米化學。在奈米級結構上的幾種化學修飾,證明了其與尺寸有關。
奈米化學的特徵是尺寸、形狀、自組裝、缺陷和生物奈米。因此,任何新的奈米結構的合成都與所有這些概念相關聯。奈米結構的合成取決於表面,尺寸和形狀如何導致構件自組裝成功能結構。它們可能具有功能缺陷,可能對電子、光子、醫學或生物分析問題有用。
二氧化矽、金、聚二甲基矽氧烷、硒化鎘、氧化鐵和碳是具有奈米化學轉化能力的材料。奈米化學可以從氧化鐵(鐵鏽)中製造出最有效的MRI造影劑,該氧化鐵具有檢測癌症甚至殺死癌症的能力。二氧化矽(玻璃)可用於彎曲或阻擋光線。發展中國家還使用矽樹脂製造流體迴路,以獲取發達國家的病原體檢測能力。碳已經以不同的形狀和形式被使用,它將成為電子材料的更好選擇。
分子奈米技術
分子奈米技術(MNT)是基於透過機械合成將結構構建為複雜的原子規格的技術。這與奈米級材料不同。基於理查德·費曼(Richard Feynman)關於使用奈米機器製造複雜產品(包括其他奈米機器)的微型工廠的願景,這種先進的奈米技術形式(或分子製造)將利用由分子機器系統引導的位置控制機械合成。MNT將涉及結合以下方面證明的物理原理生物物理學、化學,其他奈米技術和生命分子機械,以及在現代大型工廠中發現的系統工程原理。
奈米汽車
奈米汽車是在2005年設計了一個分子萊斯大學由教授為首的一批詹姆斯之旅。儘管有名稱,原始的納諾汽車並不包含分子馬達,因此,它並不是真正的汽車。相反,它旨在回答富勒烯如何在金屬表面移動的問題。具體來說,是滾動還是滑動(滾動)。
該分子由H形“底盤”組成,富勒烯基團連線在四個角上以充當輪子。
當分散在金表面上時,分子透過其富勒烯基團將其自身附著於表面,並透過掃描隧道顯微鏡進行檢測。人們可以推斷出它們的方向,因為框架長度比寬度短一些。
在將表面加熱到200°C時,分子在富勒烯“輪子”上滾動時會向前和向後移動。奈米汽車之所以能夠滾動,是因為富勒烯輪透過碳-碳單鍵安裝在炔烴 “軸”上。相鄰碳原子上的氫對自由旋轉沒有很大的阻礙。當溫度足夠高時,四個碳-碳鍵旋轉,汽車左右滾動。有時,運動方向會隨著分子的旋轉而改變。滾動作用也由萊斯大學的凱文·凱利教授透過用STM尖端拉出分子來證實。
奈米感測器
奈米感測器是測量物理量並將這些量轉換為可以檢測和分析的訊號的奈米級裝置。今天提出了幾種製造奈米感測器的方法。這些包括自上而下的光刻,自下而上的組裝以及分子自組裝。市場上和正在開發中的用於各種應用的奈米感測器型別不同。儘管所有感測器測量的都是不同的東西,但是感測器共享相同的基本工作流程:分析物的選擇性結合,奈米感測器與生物元素相互作用產生的訊號以及將訊號處理為有用的指標。
石墨烯奈米帶
石墨烯奈米帶 石墨烯奈米帶(GNR)是寬度小於50 nm 的石墨烯帶。Mitsutaka Fujita和合著者介紹了石墨烯帶作為理論模型,以研究石墨烯的邊緣和奈米級尺寸效應。
奈米馬達
奈米馬達是一個分子或奈米級能夠將能量轉換成運動的裝置。它通常可以產生力量的順序piconewtons。
儘管奈米粒子已被藝術家利用了多個世紀,例如在著名的Lycurgus杯中,但直到最近才開始對奈米技術進行科學研究。1959年,理查德·費曼(Richard Feynman)在加州理工學院舉行的美國物理學會會議上作了題為“ 底部有足夠的空間 ”的著名演講。他繼續進行科學的押注,認為沒有人能在任何一側設計出小於400 µm的電動機。下注的目的(和大多數科學上的下注一樣)是為了激勵科學家開發新技術,任何能夠開發奈米馬達的人都可以索取1000美元的獎金。但是,威廉·麥克萊倫(William McLellan)挫敗了他的目標,他在沒有開發新方法的情況下製造了納米電機。儘管如此,理查德·費曼(Richard Feynman)的演講激發了新一代科學家對奈米技術的研究。
奈米馬達因其克服低雷諾數存在的微流體動力學的能力而成為研究重點。扇貝理論解釋說,奈米電動機必須打破對稱性才能以低雷諾數產生運動。此外,必須考慮布朗運動,因為粒子與溶劑之間的相互作用會極大地影響奈米馬達穿過液體的能力。在設計新的奈米電機時,這可能會帶來嚴重的問題。當前的奈米馬達研究試圖克服這些問題,並且這樣做可以改善當前的微流體裝置或產生新技術。
奈米機器人
奈米機器人體積非常小,旨在執行復雜的任務。代表性的是,有一個由麻省理工學院開發的機器人。在探索瞭如何更好地使用該機器人之後,該團隊成功地開發了一種單元大小的機器人,該機器人可以調查其環境並存儲所收集的資訊。
該團隊沒有關注小型機器人的移動方式,而是採用了一種散射方法,該方法可能依賴於膠體系統的自然趨勢。膠體是指其中大於分子或離子的細顆粒分散在氣體或液體中的狀態。構成生物的大多數物質都可以視為膠體。
該研究的主要作者邁克爾·斯特拉諾說:“我們必須找到一種方法,使膠體顆粒與完整的電子電路相融合。” 膠體固有地容易分佈在各種型別的環境中。因此,可以將機器人放置在人體器官或管道等無法觸及的區域,以收集資料並評估這種環境下的狀況。膠體還具有在培養基中長時間停留的能力,因此研究團隊可以收集足夠的資料。
除了這種膠體流動性之外,奈米機器人還使用自己的電源進行程式設計。該團隊使用小型光電二極體產生足夠的電能來為機器人的儲存電路,處理單元和板載感測器供電。這使您可以留在現場進行長期觀察和收集資訊。
實際上,已經開發了可以透過安裝感測器來檢測環境的現有機器人。新開發的機器人可以從一分鐘到人體的內部進行調查,以提供穩定的資料集。據說機器人的發展給小型機器人帶來了新的重要性。
奈米石墨烯
奈米石墨烯是尺寸為奈米級的尺寸的石墨烯的總稱,近年來的研究一直在積極奈米碳物質。具有量子線形狀的石墨烯奈米帶(也稱為石墨烯奈米帶)也是奈米石墨烯的成員。由於體系的尺寸位於體積限制中的石墨烯片或芳族分子的中間,因此預期存在強的尺寸效應和邊緣形狀效應。另外,嚴格地將其中諸如石墨的奈米石墨烯層合的材料稱為奈米石墨。然而,由於層間距離實際上大於石墨的層間距離並且層化作用減弱,因此常常幾乎同義地處理奈米石墨和奈米石墨烯。
奈米壓印光刻
奈米壓印光刻技術是目前正在開發的一種用於半導體的精細圖案轉移技術。
常規的圖案建立縮小投影曝光裝置(步進器)已被使用,小型化由於,極紫外曝光裝置和金錢和圖案掩模飛漲,猶豫半導體制造商引入已經相繼被阻止。如果奈米壓印光刻技術普遍增加生產率,則有望xxx到的半導體制造成本的降低做出貢獻。
1995年,普林斯頓大學的 Chou等人提出了一種熱迴圈奈米壓印方法。作為解析度約為10nm的處理技術,它引起了人們的關注。
在熱迴圈奈米壓印法中,將抗蝕劑塗覆在矽基板上,加熱至200℃並軟化,然後使由電子束光刻系統形成的模具緊密接觸,然後冷卻以形成圖案。但是,由於進行加熱和冷卻,因此單位時間的處理能力低,尺寸精度存在問題。
另一方面,存在使用紫外線固化樹脂的光學奈米壓印技術。這不同於熱迴圈奈米壓印,加熱,還有一個優點,即,因為它不冷卻與其相關聯的熱膨脹,也不會發生與熱收縮的問題。
對準(定位)的精度很重要,如果將奈米壓印應用於22 nm設計規則,則對準精度必須為3 nm或更小,這是一個瓶頸。此外,由於其與晶片接觸,存在由於使用期間的掩模汙染而導致汙染的風險,並且需要頻繁檢查。這些問題的解決已成為傳播的問題。
DNA奈米技術
DNA奈米技術(英文:DNA nanotechnology)是一種人為設計併產生有用的核酸結構的技術。儘管它以DNA命名,但由於使用了其他型別的核酸,因此還有一個“核酸奈米技術”的名稱。在這一領域,核酸被用作非生物奈米材料,而不是用作活細胞的遺傳資訊載體。在先前的研究中,已經制造出使用DNA,奈米管,多面體和任意形狀的靜態結構的2D和3D 晶格,並且已經獲得了諸如分子機器和DNA計算機之類的功能裝置。是的 X射線結構分析和核磁共振波譜法透過蛋白質的結構,例如識別,結構生物學和生物物理學中的基本問題它開始被用作解決問題的工具。未來的分子規模電子學及其在奈米醫學中的應用也正在研究中。
以上都是最新的奈米技術應用場景,謝謝朋友閱讀我的文章,還請動動你的小手點贊支援,然後發表你的觀點。